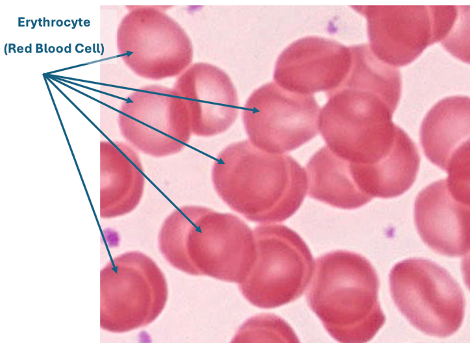
<p>Describe ONE structural feature visible in this slide</p>
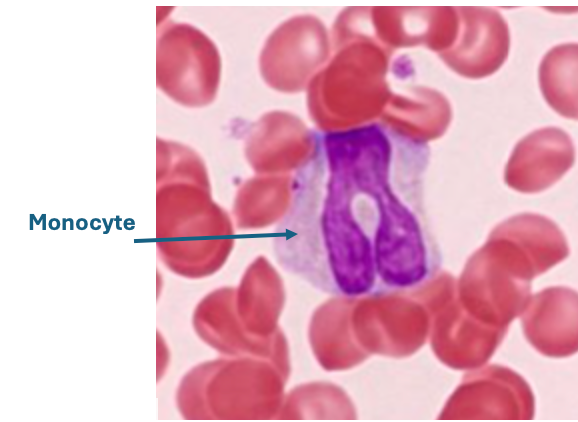
<p>This cell is classified as a __________</p>
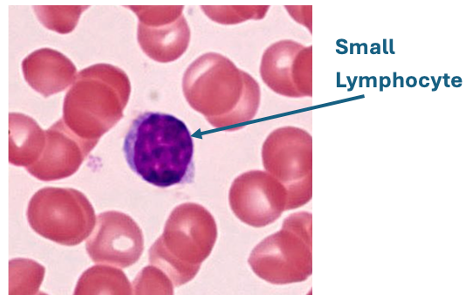
<p>This cell is capable of __________</p>
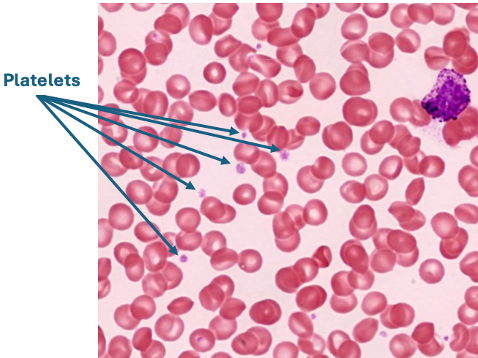
<p>What is its function? __________</p>

fill in the blank - ch 18 blood
1/37
There's no tags or description
Looks like no tags are added yet.
Name | Mastery | Learn | Test | Matching | Spaced | Call with Kai |
|---|
No analytics yet
Send a link to your students to track their progress
38 Terms
Formed elements make up ______% of blood volume and plasma makes up ______%
~45%, ~55%
The average pH of blood is _______
7.4
The three types of formed elements are __________, __________, and __________
erythrocytes, leukocytes, platelets
Blood is classified as a __________ tissue
connective
Over 90% of plasma is __________
water
Erythrocytes are also called __________
red blood cells
The most abundant blood cell type (about 98%) is __________
erythrocytes
Platelets are cell fragments involved in __________
blood clotting
Neutrophils are classified as __________ (granulocyte or agranulocyte)
granulocyte
Monocytes are classified as __________
agranulocyte
Lymphocytes are capable of __________
mitosis
A person with blood type A+ has ______ antigen and ______ antigen on RBCs
A, Rh
A person with blood type B− has only ______ antigen
B
A person with blood type O− has ______ antigens on RBCs
no
A person with blood type AB+ produces ______ antibodies
no
A person with blood type O+ produces ______ and ______ antibodies
anti-A, anti-B
The buffy coat contains __________ and __________
leukocytes, platelets
Hematocrit is defined as the percentage of __________ in blood
red blood cells
A low hematocrit is called __________
anemia
Hemoglobin is important because it carries __________
oxygen
Normal fasting blood glucose range is ______ to ______ mg/dL
70 to 100
If a blood sample agglutinates with anti-B and anti-Rh serum only, the blood type is __________
B+
If a person lacks A antigen, they will produce __________ antibodies
anti-A
The equation for hematocrit is: __________ / __________ × 100
height of RBCs / total blood height
The least common blood type is __________
AB−
Describe ONE structural feature visible in this slide
biconcave shape / no nucleus / pink cytoplasm
This cell is classified as a __________
agranulocyte
This cell is capable of __________
mitosis
What is its function? __________
blood clotting

Blood type = __________
O−

The top layer of a centrifuged blood tube is __________
plasma

The middle layer (buffy coat) of a centrifuged blood tube contains __________ and __________
leukocytes and platelets

The bottom layer of a centrifuged blood tube consists of __________
erythrocytes

Hematocrit = __________ %
45%

A hematocrit value of 45% is (normal/high/low)?
normal

Identify AND give % of total cells
Erythrocyte, ~98%
A patient with AB+ blood can receive blood from __________
all blood types
A person with type B− blood has __________ and __________ antibodies
anti-A and anti-Rh